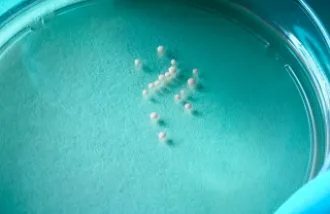
3-D brain cultures in a lab dish

Displaying 781 - 800 news posts of 1425
By disabling a protein in the brain’s blood vessels, researchers ease age-related deterioration in mice
Scientists have shown that delivering blood from an old mouse into a young mouse or vice versa prompts a sort of “Freaky Friday” effect: The brains of the young mice exposed to the old blood lose vitality, while the young blood rejuvenates some brain func
Blocking protein curbs memory loss in old mice
Impeding VCAM1, a protein that tethers circulating immune cells to blood vessel walls, enabled old mice to perform as well on memory and learning tests as young mice, a Stanford study found.
A new technique to examine how flatworms re-grow their limbs and organs could one day help scientists understand how human brains recover from stroke or traumatic injury.
A new technique to examine how flatworms re-grow their limbs and organs could one day help scientists understand how human brains recover from stroke or traumatic injury.
Molecule on brain blood-vessel walls may contribute to aging-related forgetfulness
Old mice suffered far fewer senior moments on memory tests when Stanford investigators disabled a single molecule dotting the mice’s cerebral blood vessels.
Why Dance Matters
OK, OK, it can be intimidating. You have to follow the beat and maybe even put yourself in uncomfortable proximity to total strangers. But the cognitive and emotional payoffs, say faculty, students and patients, are profound.
Caregiving for a partner with brain cancer: A personal story
In this essay, which originally appeared in Months to Years, writer Nicole Hardina reflects on caregiving for her partner who was dying of brain cancer.
In This Doctor’s Office, a Physical Exam Like No Other
Genetic and molecular analysis of 109 volunteers turned up hidden health problems in about half of them. Critics say the approach amounted to ‘carpet-bombing’ the body.
Study shows how big data can be used for personal health
Years-long tracking of individuals’ biology helped define what it meant for them to be healthy and showed how changes from the norm could signal disease, a Stanford-led study reports.
Stanford researchers identify brain region activated by Pokémon characters
Adults who played Pokémon videogames extensively as children have a brain region that responds preferentially to images of Pikachu and other characters from the series.
New research links brain injury from low oxygen to specific cells
Low oxygen levels during brain development may cause particular cells to differentiate too soon, a Stanford-led study found.
Sleeping pills: A risk of car crashes, gunshot wounds and Jason Bourne amnesia
Millions of Americans take millions of sleeping pills every year — a sign, many experts say, that human beings weren’t designed to live in a wired world of constant stimulation.
Hormone reduces social impairment in kids with autism
In a Stanford study of 30 children with autism, intranasal vasopressin improved social skills more than a placebo, suggesting that the hormone may treat core features of the disorder.
Stanford Pushes Executives to Get ‘Touchy Feely’
University’s M.B.A. program seeks new revenue by offering popular emotional intelligence course to working people; ‘This isn’t therapy’
Can manipulating a ‘social’ hormone’s activity treat autism?
Opposite approaches to altering the activity of vasopressin in the brain improved some social deficits in people with autism.
Three faculty elected to National Academy of Sciences
Karla Kirkegaard, Mark Krasnow and William Weis are now part of an organization created in 1863 to advise the nation on issues related to science and technology.
Your Brain Comes with Noise Canceling
A team of scientists at Duke University, sought to understand how the brain predicts and turns down sounds that arise during self-movement.